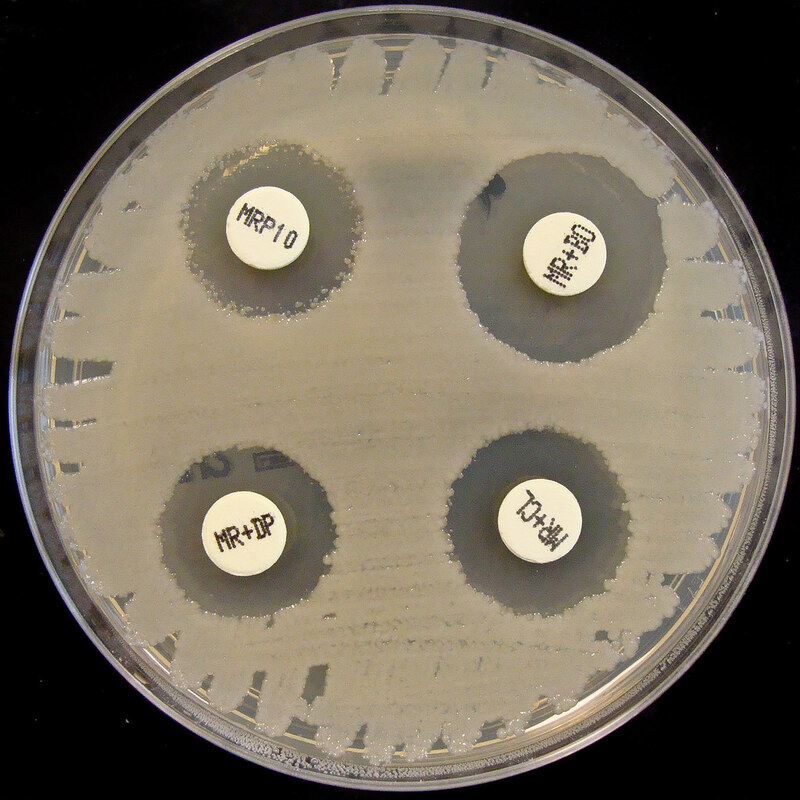
Масс-спектрометрия нативного состояния может идентифицировать лекарственные препараты для борьбы с резистентными бактериями

Метод, называемый масс-спектрометрией нативного состояния, может позволить ученым оценить, как потенциальные ингибиторы действуют на антибиотикоустойчивые бактерии, говорится в исследовании, представленном на World Microbe Forum.
"Основным направлением исследований нашей лаборатории является определение механизма ингибирования потенциальных ингибиторов металло-бета-лактамаз (МБЛ) с помощью различных спектроскопических методов", - рассказала в интервью Healio Кейтлин А. Томас, из Университета Майами. "Кроме того, наша лаборатория широко изучила эволюцию наиболее клинически значимых металло-бета-лактамаз", включая металло-бета-лактамазу 1 из Нью-Дели (NDM-1), металло-бета-лактамазу 2 из Вероны, кодируемую интегроном (VIM-2) и IMP-1.
Металло-бета-лактамазы могут сделать многие клинически значимые штаммы бактерий резистентными ко всем пенициллиноподобным антибиотикам. Томас объяснила, что имипенемаза (IMP) эволюционировала для преодоления структурных различий бета-лактамных антибиотиков, а вариант IMP-1, IMP-78, имеет две мутации вблизи активного сайта и демонстрирует наиболее резкое изменение резистентности к некоторым бета-лактамам по сравнению с IMP-1.
"Ранее я изучала механизм ингибирования различных ингибиторов с помощью VIM-2, оптимизируя использование масс-спектрометрии нативного состояния, поэтому эта комбинация заставила меня задаться вопросом, будут ли варианты ингибироваться таким же образом, как и их прародитель", - сообщила Томас. "Например, если ингибитор работает с IMP-1 - если он способен связываться с IMP-1 и ингибировать его - будет ли он также способен ингибировать IMP-78?".
Томас и ее коллеги использовали молекулярное моделирование и масс-спектрометрию нативного состояния для быстрого скрининга с помощью уникальной методики, которая позволяет сохранить белок в нативном состоянии, а не фрагментировать образец, как это происходит при использовании других методов масс-спектрометрии, чтобы определить, способны ли различные ингибиторы ингибировать IMP-1 и вариант IMP-78. Она отметила, что исследование продолжается, но пока оно показало, что существуют различия в ингибировании между IMP-1 и IMP-78. "Я обнаружила, что некоторые из изучаемых мною ингибиторов способны связываться с IMP-1, но не связываются с IMP-78", - сказала она. "Это означает, что они демонстрируют различные механизмы ингибирования родительского и вариантного ферментов".
По словам Томас, это исследование имеет как ближайшие, так и долгосрочные последствия. В первую очередь, оно подчеркивает тот факт, что варианты IMP-1 уникальны и потенциально демонстрируют различные механизмы ингибирования по сравнению с IMP-1. В долгосрочной перспективе это означает, что ученым необходимо будет учитывать эти различия при разработке будущих ингибиторов.
"Клинический вывод заключается в важности включения вариантов IMP-1, VIM-2 и NDM-1 - наряду со всеми другими металло-бета-лактамазами - в разработку ингибиторов",
- сказала Томас.
"Цель состоит в том, чтобы разработать ингибитор широкого спектра действия, который можно было бы использовать в паре с бета-лактамным антибиотиком и который был бы способен ингибировать все клинически значимые металло-бета-лактамазы. Однако многие исследования направляют свои усилия на изучение только ингибиторов NDM-1, VIM-2 или IMP-1", - сказала она.
"Я надеюсь, что результаты этого исследования показывают важность включения вариантов в разработку ингибиторов, поскольку металло-бета-лактамазы продолжают эволюционировать и представляют все большую угрозу в клинике".